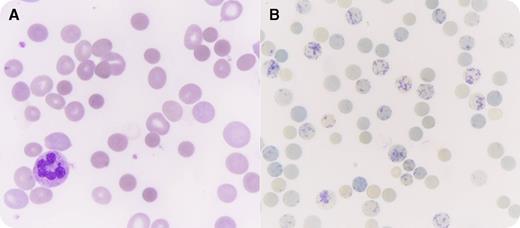
A 47-year-old white woman, who was an active smoker, was referred to the emergency department for the recent onset of exertional dyspnea with chest pain. She did not have a remarkable medical history or family history of anemia and received no medications, although she took pain medication occasionally. Her clinical examination revealed pallor and conjunctival jaundice with mild hepatosplenomegaly. She displayed isolated macrocytic (mean corpuscular volume, 125 fL) anemia (hemoglobin, 4.2 g/dL). An elevated automated reticulocyte count (603 × 109/L) was confirmed by supravital staining with brilliant cresyl blue (panel B; many cells display a typical blue-stained reticulum, original magnification ×1000). Hemolysis was confirmed (lactate dehydrogenase, 2866 IU/L; bilirubin, 62 µmol/L; haptoglobin, <0.1 g/L). The direct antiglobulin test (DAT) was originally negative, however, the examination of the blood smear showed numerous spherocytes (panel A; May-Grünwald–Giemsa stain shows sphere-shaped erythrocytes, original magnification ×1000) that looked consistent with autoimmune hemolytic anemia (AIHA) in the absence of a familial hemolysis history. Hence, a new extensive DAT was performed and revealed the presence of erythrocyte-bound immunoglobulin A (IgA) autoantibodies. Additional exploration revealed chronic nonactive hepatitis C. The severe AIHA was treated with corticosteroids, rituximab, azathioprine, and eventually responded to splenectomy. / Such DAT-negative AIHAs remain rare (∼3%-5% of all AHAIs). Warm IgA antibody AIHAs represent 1% to 2% of all warm AIHAs. This case highlights the relevance of careful blood-smear examination, which can avoid costly investigation of unexplained hemolytic anemia.

A 47-year-old white woman, who was an active smoker, was referred to the emergency department for the recent onset of exertional dyspnea with chest pain. She did not have a remarkable medical history or family history of anemia and received no medications, although she took pain medication occasionally. Her clinical examination revealed pallor and conjunctival jaundice with mild hepatosplenomegaly. She displayed isolated macrocytic (mean corpuscular volume, 125 fL) anemia (hemoglobin, 4.2 g/dL). An elevated automated reticulocyte count (603 × 109/L) was confirmed by supravital staining with brilliant cresyl blue (panel B; many cells display a typical blue-stained reticulum, original magnification ×1000). Hemolysis was confirmed (lactate dehydrogenase, 2866 IU/L; bilirubin, 62 µmol/L; haptoglobin, <0.1 g/L). The direct antiglobulin test (DAT) was originally negative, however, the examination of the blood smear showed numerous spherocytes (panel A; May-Grünwald–Giemsa stain shows sphere-shaped erythrocytes, original magnification ×1000) that looked consistent with autoimmune hemolytic anemia (AIHA) in the absence of a familial hemolysis history. Hence, a new extensive DAT was performed and revealed the presence of erythrocyte-bound immunoglobulin A (IgA) autoantibodies. Additional exploration revealed chronic nonactive hepatitis C. The severe AIHA was treated with corticosteroids, rituximab, azathioprine, and eventually responded to splenectomy.
Such DAT-negative AIHAs remain rare (∼3%-5% of all AHAIs). Warm IgA antibody AIHAs represent 1% to 2% of all warm AIHAs. This case highlights the relevance of careful blood-smear examination, which can avoid costly investigation of unexplained hemolytic anemia.
A 47-year-old white woman, who was an active smoker, was referred to the emergency department for the recent onset of exertional dyspnea with chest pain. She did not have a remarkable medical history or family history of anemia and received no medications, although she took pain medication occasionally. Her clinical examination revealed pallor and conjunctival jaundice with mild hepatosplenomegaly. She displayed isolated macrocytic (mean corpuscular volume, 125 fL) anemia (hemoglobin, 4.2 g/dL). An elevated automated reticulocyte count (603 × 109/L) was confirmed by supravital staining with brilliant cresyl blue (panel B; many cells display a typical blue-stained reticulum, original magnification ×1000). Hemolysis was confirmed (lactate dehydrogenase, 2866 IU/L; bilirubin, 62 µmol/L; haptoglobin, <0.1 g/L). The direct antiglobulin test (DAT) was originally negative, however, the examination of the blood smear showed numerous spherocytes (panel A; May-Grünwald–Giemsa stain shows sphere-shaped erythrocytes, original magnification ×1000) that looked consistent with autoimmune hemolytic anemia (AIHA) in the absence of a familial hemolysis history. Hence, a new extensive DAT was performed and revealed the presence of erythrocyte-bound immunoglobulin A (IgA) autoantibodies. Additional exploration revealed chronic nonactive hepatitis C. The severe AIHA was treated with corticosteroids, rituximab, azathioprine, and eventually responded to splenectomy.
Such DAT-negative AIHAs remain rare (∼3%-5% of all AHAIs). Warm IgA antibody AIHAs represent 1% to 2% of all warm AIHAs. This case highlights the relevance of careful blood-smear examination, which can avoid costly investigation of unexplained hemolytic anemia.
For additional images, visit the ASH IMAGE BANK, a reference and teaching tool that is continually updated with new atlas and case study images. For more information visit http://imagebank.hematology.org.
This feature is available to Subscribers Only
Sign In or Create an Account Close Modal